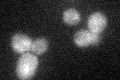

View description
Protein that functions in a complex with Kel1p to negatively regulate mitotic exit, interacts with Tem1p and Lte1p; localizes to regions of polarized growth; potential Cdc28p substrate
Localization:
Intensity:
Fold change:
Significance:
-
C’ GFP library in SD

bud neck -
N' NOP1pr-GFP in SD

bud,bud neck51.1727 -
N' TEF2pr-mCherry in SD

bud neck45.4936 -
N' NATIVEpr-GFP in SD

below threshold14.1908 -
N' TEF2pr-VC and Cyto-VN in SD

cytosol,bud38.2319 -
C’ GFP library in SD+DTT

bud neck20.120.96No -
C’ GFP library in SD+H2O2
bud neck20.370.97No -
C’ GFP library in Starvation Media

punctateN/AN/AYes -
C’ GFP library on the background of Pup2-DaMP

bud neck -
C’ GFP library on the background of CCT mutant

bud neck21.1511.01536No
